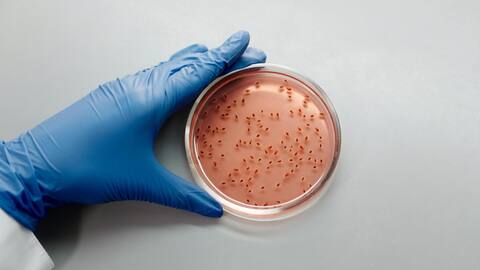

Mikroorganisme yang Membersihkan Tumpahan Minyak di Seluruh Dunia
Apa ceritanya
Tumpahan minyak merupakan masalah lingkungan yang serius, mengancam ekosistem laut dan kehidupan manusia. Namun, mikroorganisme hadir sebagai solusi alami untuk membersihkan tumpahan minyak ini. Mikroorganisme tertentu memiliki kemampuan untuk memecah senyawa minyak menjadi bahan yang lebih aman bagi lingkungan. Artikel ini akan membahas bagaimana mikroorganisme berperan dalam membersihkan tumpahan minyak di seluruh dunia.
Konsep Utama
Peran Mikroorganisme dalam Bioremediasi
Bioremediasi adalah proses penggunaan mikroorganisme untuk menguraikan polutan seperti minyak. Mikroba seperti bakteri dan jamur dapat memakan hidrokarbon dalam minyak, mengubahnya menjadi air dan karbon dioksida. Proses ini tidak hanya efektif tetapi juga ramah lingkungan karena tidak meninggalkan residu berbahaya. Dengan memahami peran mikroba ini, kita dapat lebih baik menangani tumpahan minyak secara alami.
Manfaat
Keuntungan Menggunakan Mikroorganisme
Menggunakan mikroorganisme untuk membersihkan tumpahan minyak memiliki banyak keuntungan. Pertama, metode ini lebih murah dibandingkan dengan teknik pembersihan mekanis atau kimiawi lainnya. Kedua, bioremediasi tidak merusak ekosistem lokal karena menggunakan proses alami yang sudah ada di alam. Ketiga, metode ini dapat diterapkan pada berbagai jenis lingkungan, dari pantai hingga laut lepas.
Tantangan
Tantangan dan Solusi
Meskipun menjanjikan, penggunaan mikroorganisme dalam bioremediasi menghadapi beberapa tantangan. Salah satunya adalah waktu yang dibutuhkan untuk proses pembersihan bisa cukup lama tergantung pada kondisi lingkungan dan jenis minyak yang terlibat. Selain itu, suhu dan salinitas air juga mempengaruhi efektivitas mikroba tersebut. Penelitian terus dilakukan untuk meningkatkan efisiensi bioremediasi melalui rekayasa genetika atau penambahan nutrisi tertentu.
Masa Depan
Masa Depan Bioremediasi
Masa depan bioremediasi terlihat cerah dengan kemajuan teknologi dan penelitian ilmiah yang terus berkembang. Inovasi baru memungkinkan identifikasi spesies mikroba yang lebih efektif serta pengembangan teknik aplikasi yang lebih efisien di lapangan. Dengan dukungan dari komunitas global dan investasi dalam penelitian lanjutan, bioremediasi bisa menjadi solusi utama dalam menangani tumpahan minyak secara berkelanjutan di masa depan.